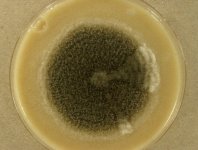

<< back to search
IMAGES:





Search Details
add to cart
| UAMH Number: | 11605 |
|---|---|
| Species Name: | Cephalotrichum stemonitis |
| Type: | |
| Synonyms: | Cephalotrichum setosum / Ceratopodium subulatum / Ceratopodium typhinum / Doratomyces neesii / Doratomyces stemonitis / Doratomyces stemonitis var. kerationolytica / Echinobotryum atrum / Echinobotryum parasitans / Graphium subulatum / Graphium typhinum / Isaria stemonitis / Pachnocybe subulata / Periconia setosa / Periconia stemonites / Periconia stemonitis / Periconia stemonitis var. communis / Periconia stemonitis var. pusilla / Periconia subulata / Sporocybe setosa / Stilbum setosum / Stilbum subulatum / Stilbum typhinum / Stysanus capitatus / Stysanus ramifer / Stysanus stemonites / Stysanus stemonitis / Stysanus stemonitis var. ramosa / Stysanus stemonitis var. stemonitis / Stysanus tubericola |
| Taxonomy: | FUNGI Ascomycota, Sordariomycetes, Microascales, Microascaceae |
| Strain History: | Vanderwolf, K.J. (Bat 18 S fur) -> UAMH |
| Substrate: | swab, fur of bat | Location: | CANADA New Brunswick, Howes Cave (GEO: 42.69,-74.383) |
| Isolator: | K.J. Vanderwolf |
| Isolation Date: | 2010-01-21 |
| Date Received: | 2011-11-16 |
| Characters: | BIODIVERSITY mycobiota of bat caves // CULTURE CONDITIONS produced Echinobotryum synanamorph |
| Compounds: | |
| Cross Reference: | Untereiner WUC C18 |
| Pathogenic Potential: | Human: no | Animal: no | Plant: no |
| Biosafety Risk Group: | RG1 (check the PHAC ePATHogen Risk Group Database for updates) |
| Regulatory Requirements: | No restrictions for Canadian requesters. International requesters must provide all legally required importation documentation prior to shipment. Plant pathogenicity status may be verified by using the USDA Agricultural Research Service (ARS) Fungal Database |
| MycoBank ID: | 223989 |
IMAGES: